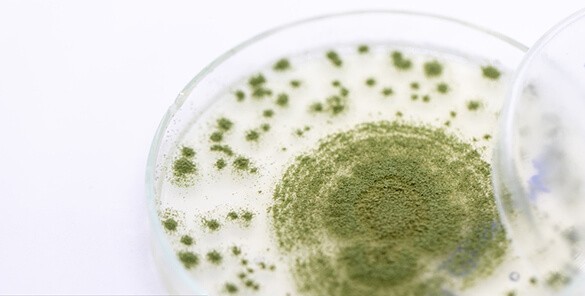
INDUSTRY

The dairy industry is one of the most important food-producing sectors in the world. There is a great deal of diversity in the types of dairy products available, from milk to butter to cheese to quark to yogurt. In order to produce high-quality milk and dairy products, proper separation technology is required for improving efficiency and keep hygiene and gentle result. This is where HUADING disc separator comes in.
Disc separators are machines used to separate raw milk into its valuable component parts. The disc separator is a rotating bowl with a series of discs that spin at high speeds. The milk is fed into the separator and forced through the discs by centrifugal force. The different components of the milk are then separated and collected in separate containers. The advanced inlet and outlet design of HUADING separator guarantees soft treatment during the whole separation process.
Production and recovery of:
━ Casein
━ Cheese dust
━ Quark
━ Cream cheese
━ Lactose
━ Whey protein
━ Butter
━ Butter oil
━ Calcium phosphate
If you are looking for a disc separator for your business, we can help you find the right one for your needs. We offer a wide variety of disc separators, from small to large, and we can customize a separator to meet your specific requirements.